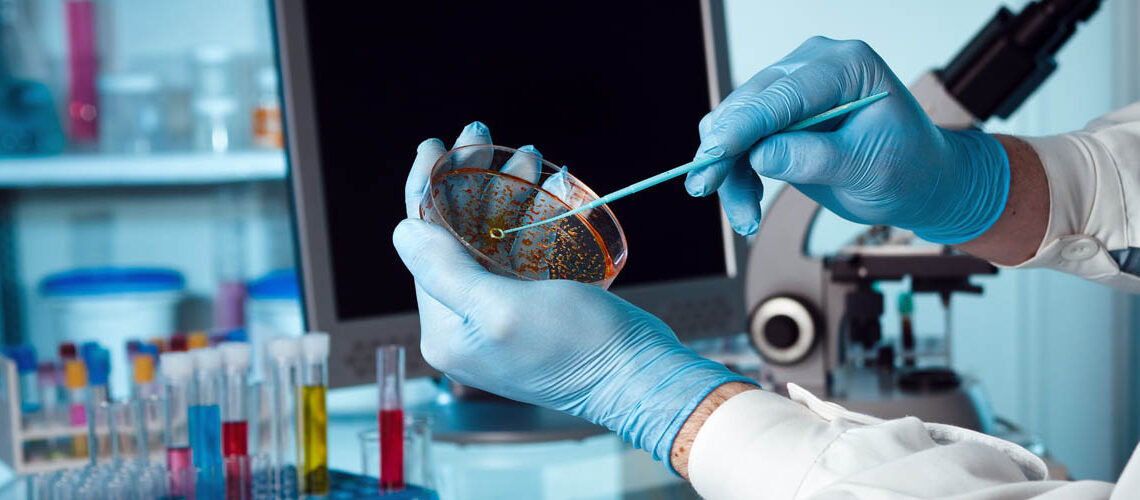
Αύριο Τετάρτη 25 Μαρτίου επίσκεψη ιατρού σε Δαμασκηνιά και Δραγασιά

Με την αριθ. 8831/16-03-2020 Απόφαση του Γενικού Γραμματέα Πολιτικής Προστασίας, τα χωριά Δαμασκηνιάς και Δραγασιάς, τέθηκαν σε κατάσταση έκτακτης ανάγκης. Από την πρώτη στιγμή η δημοτική αρχή, προσπάθησε να εξασφαλίσει είτε μέσω των κρατικών αρμοδίων φορέων είτε μέσω του ιδιωτικού τομέα υγείας, την επίσκεψη ιατρού και την διενέργεια διαγνωστικών ελέγχων στους κατοίκους των χωριών Δαμασκηνιάς και Δραγασιάς. Μετά από εκτεταμένες και επίμονες παρεμβάσεις προς τους φορείς που διαχειρίζονται την υγειονομική κρίση της πανδημίας, ανακοινώνουμε ότι την Τετάρτη 25-03-2020, ιατρός θα επισκεφθεί τα χωριά της Δαμασκηνιάς και Δραγασιάς για να πραγματοποιήσει διαγνωστικούς ελέγχους σε κατοίκους που κρίνεται αναγκαίο. Προσωπικό του Δήμου θα επικοινωνήσει τηλεφωνικά με τους κατοίκους, προκειμένου να τους ενημερώσει σχετικά με τον τρόπο προσέλευσή τους και την διενέργεια της εξέτασης σύμφωνα με τα ισχύοντα μέτρα και πρωτόκολλα.
Από το Γραφείο Δημάρχου